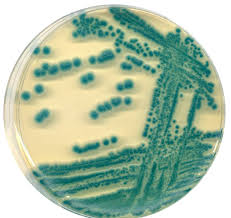

İçeriğe geç
- hareketli, gram pozitif, çubuk şeklinde, Katalaz pozitif,
spor oluşturan, fakültatif anaerob bakteridir.(Bkz; Bacillus ) (Bkz; cereus)
spor oluşturan, fakültatif anaerob bakteridir.(Bkz; Bacillus ) (Bkz; cereus)
- Bacillus cereus’un sayıca fazla olarak insan vücuduna girmesi sonucu, gıda zehirlenmesi görülür.
- Zehirlenme(kulukça süresi; 1-5 saat); bulantı, kusma
- Enfeksiyon (kuluçka süresi; 4-16 saat); bakteri hücreleri ve sporların alınması ile bağırsakta enterotoksin oluşur.Karın ağrısı, ishal gözlemlenir.
- Yara enfeksiyonu, Endophtalmitis, Endokarditis, Pneumonie‘ye sebep olur.
spor oluşturan, fakültatif anaerob bakteridir.(Bkz; Bacillus ) (Bkz; cereus)